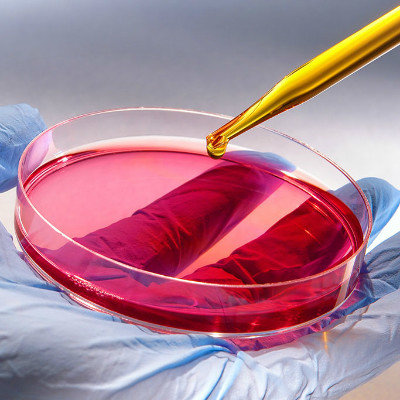

What does mercury poison need to eat?
summary
At the time of the Dragon Boat Festival, I brought some rice dumpling leaves to my home. I wanted to say that they were planted by my family. I took some to my aunt downstairs. Because I had been sending me delicious food before, when I arrived at the room, I found that my aunt was very pale and uncomfortable. I used to ask her that she had been very uncomfortable, dizzy and nauseous recently, There were also symptoms of diarrhea, so I took my aunt to the hospital as soon as possible. I had several tests and said that it was mercury poisoning. It turned out that my aunt's factory was a lighting factory, which belonged to chronic poisoning. Let's have a look.
What does mercury poison need to eat?
Acute poisoning usually takes about 10 minutes to have symptomatic reactions. Oral cavity and intestines and stomach will be corroded in a short time, throat burns, nausea, abdominal pain, diarrhea and vomiting. Vomitus and faeces can carry blood mucus, and even cause gastric perforation, which is very serious. Therefore, it is necessary to see a doctor in time. Otherwise, it will do great harm.
The production activities of mercury exposure include lighting, thermometers, pharmaceuticals, instruments, extraction of gold and silver, etc. the symptoms of chronic poisoning generally include dizziness, insomnia, headache, easy to wake up at night, blushing, sweating, restlessness, etc. There may also be oral ulcers, swollen gums, tooth loss.

Mercury is a kind of white commercial metal, so mercury poisoning also refers to mercury poisoning. Generally, mercury poisoning can be divided into chronic poisoning and acute poisoning. Chronic poisoning is more common. It generally refers to the inhalation of mercury or some mercury dust after mercury volatilization. Mercury poisoning is common in production activities.

matters needing attention
Mild chronic mercury poisoning is very good to cure, so don't worry too much, but usually pay more attention to prevention, if there is contact with mercury in production, we should carry out regular physical examination every year, find out the poisoning situation in time, and see a doctor as soon as possible. At the same time, pay more attention to the use of non-toxic products instead of mercury products in life.










